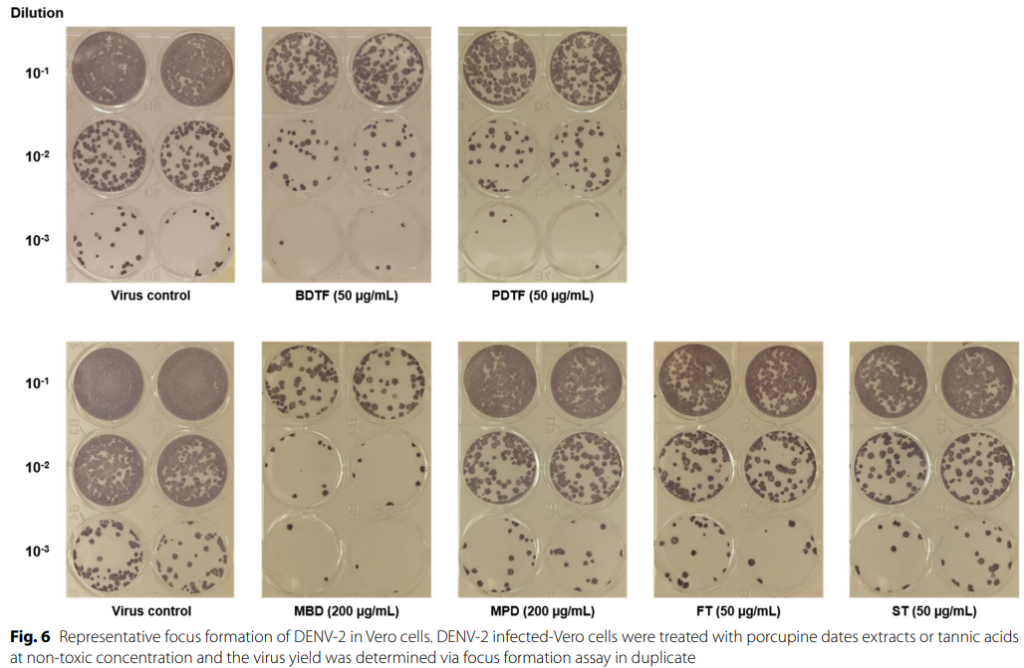

在一些现代医学的体外(in vitro) 研究, “箭猪枣”含有抗氧化及清除自由基, 活性氧/活性氮的成分, 可以抑制肿瘤血管的生成, 进而可控制肿瘤生长及转移。
*不过仍缺乏体内研究的证据。也即是还不能说有治癌的疗效!
01/03
箭猪枣用于治疗蚊症
箭猪枣是东南亚地区人们用来治疗蚊症的传统药物之一。


02/03
BDTF与PDTF抗毒活性高达药物5–6倍
箭猪枣内含有丰富的PDFT,BDTF,已经单宁酸研究表示 PDFT和BDFT拥有蚊症病毒的抗毒活性,可抑制病毒的活性
03/03
PDFT与BDTF显著抑制蚊症病毒
研究证明了 BDTF与PDTF的抗毒活性分别是普通药物的5至6倍。研究也表明了单宁酸内的BD和PC分离物的抗病毒活性也明显高于与甲醇粗提物。这可以显著证明箭猪枣对于对抗蚊症的有效性。


为什么选择同心圆
同心圆成立于2004就专注箭猪枣研究,坚持真材实料、科学检测。从选材、技术到认证,我们不仅是卖保健品,更是陪伴癌症患者调理的专业团队。选择同心圆,是对疗效负责,对身体负责。
- 经SGS、USM等国际实验室认证,成分含量有实测报告
- 全马首创箭猪枣纳米萃取技术,吸收率高达99%,调理见效更快
- 含三大抗癌关键成分:菠萝蛋白酶、植物固醇、单宁,浓度远超传统中药材